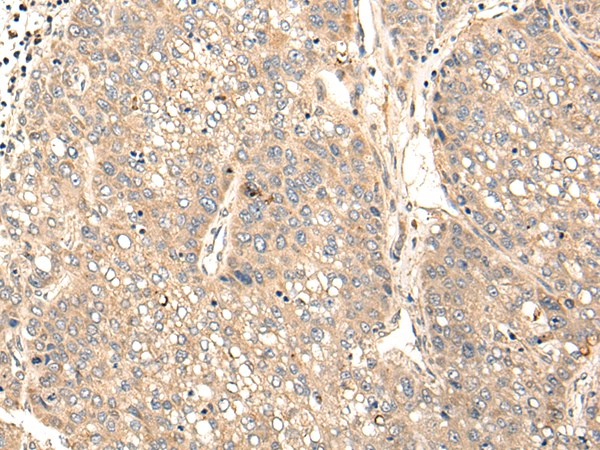

|
Background: |
The protein encoded by this gene contains a proline-rich region, a pleckstrin homology (PH) domain, and a region in the carboxy terminal half with similarity to the Src Homology 2 (SH2) domain. This protein is a substrate of tyrosine-protein kinase Tec, and its interaction with tyrosine-protein kinase Tec is phosphorylation-dependent. This protein is thought to participate in a positive feedback loop by upregulating the activity of tyrosine-protein kinase Tec. Variants of this gene have been associated with autosomal-dominant hypercholesterolemia (ADH), which is characterized by elevated low-density lipoprotein cholesterol levels and in increased risk of coronary vascular disease. Alternative splicing results in multiple transcript variants. |
|
Applications: |
ELISA, IHC |
|
Name of antibody: |
STAP1 |
|
Immunogen: |
Fusion protein of human STAP1 |
|
Full name: |
signal transducing adaptor family member 1 |
|
Synonyms: |
BRDG1; STAP-1 |
|
SwissProt: |
Q9ULZ2 |
|
ELISA Recommended dilution: |
5000-10000 |
|
IHC positive control: |
Human liver cancer and human esophagus cancer |
|
IHC Recommend dilution: |
25-100 |

購物車
購物車 幫助
幫助
 021-54845833/15800441009
021-54845833/15800441009
